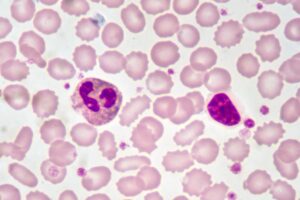
Low Neutrophils and High Lymphocytes: Causes and Implications

Low neutrophils and high lymphocytes usually indicate your immune system is responding to an infection or other health conditions. This article explains what these changes mean and how they might affect your health.
Key Takeaways
- Low neutrophil and high lymphocyte counts can signal underlying health issues, including infections, autoimmune disorders, or cancers.
- Management of abnormal white blood cell counts involves treating underlying causes and may require monitoring, medication adjustments, or therapies like chemotherapy.
- A balanced lifestyle, including a healthy diet and stress management, can help support immune health and potentially improve white blood cell counts.
Low Neutrophils and High Lymphocytes
White blood cells, or leukocytes, are essential in defending our bodies against infections. Produced from myeloid stem cells in the bone marrow, these cells circulate through our bloodstream and tissues, always on the lookout for invaders.
Neutrophils and lymphocytes are two primary types of these cells that play distinct roles in our immune response.
Low neutrophil and high lymphocyte counts can indicate that the body is under some form of stress, often due to infections or other medical conditions.
Normally, lymphocytes make up 20-40% of circulating white blood cells, but an imbalance can affect the immune response significantly. Such imbalances increase the risk of infections and complicate the body’s ability to fight diseases effectively.
Common Causes of Low Neutrophil Count
One of the most common causes of a low neutrophil count is undergoing chemotherapy or radiation treatment. These treatments, while effective against cancer, often damage bone marrow, leading to decreased neutrophil production. Similarly, certain medications, including antipsychotics and anti-inflammatory drugs, can also lower neutrophil levels.
Infections, both bacterial and viral, can lead to a significant drop in neutrophils. Severe infection and viral infections often cause neutrophils to be used up faster than they can be produced. This was something I experienced firsthand during a particularly nasty bout of the flu.
Autoimmune disorders like lupus and rheumatoid arthritis can also be culprits. In these conditions, the body’s immune system mistakenly attacks its own cells, including neutrophils, leading to a reduced count. Additionally, bone marrow disorders such as aplastic anemia and leukemia directly affect the production of neutrophils.
Sometimes, an overactive spleen filters out white blood cells excessively, leading to lower counts. This condition, known as splenomegaly, can also contribute to low neutrophil levels. Understanding these causes helps in pinpointing the exact reason behind a low neutrophil count, allowing for more targeted treatments.
Common Causes of High Lymphocyte Count
Infections often trigger high lymphocyte counts. Viral infections such as cytomegalovirus and mononucleosis can significantly increase lymphocyte levels. For example, mononucleosis can lead to extraordinarily high lymphocyte counts.
Chronic infections and autoimmune diseases can lead to persistently high lymphocyte levels. Conditions like chronic lymphocytic leukemia (CLL), a type of blood cancer, are characterized by an overproduction of lymphocytes. These lymphocytes are often ineffective, making the situation even more complicated.
- Infections: Viral and bacterial infections are common triggers for lymphocytosis.
- Autoimmune Disorders: Chronic inflammation from diseases like lupus can elevate lymphocyte counts.
- Cancers: Hematological disorders, including different types of leukemia, can lead to increased lymphocyte production.
Addressing the underlying cause, such as treating infections or managing autoimmune conditions, is key to managing elevated lymphocyte levels. In some severe cases, treatments like chemotherapy or radiation may be necessary.
White Blood Cells in Immune Response
Neutrophils act as the first responders in our immune system. They rush to the site of infection, attacking bacteria, fungi, and foreign debris, thus playing a crucial part in our innate immunity. Elevated neutrophil levels usually indicate an acute inflammatory response, signaling that the body is fighting off an infection.
Lymphocytes, on the other hand, are key players in the adaptive immune response. This group includes T cells and B cells, which are responsible for targeting viral infections and producing antibodies. High lymphocyte levels often indicate a strong adaptive immune response, which can be triggered by viral infections or chronic inflammatory conditions.
The balance between neutrophils and lymphocytes is vital for maintaining immune homeostasis. An imbalance might reflect underlying health issues, as these cells coordinate to defend against infections. Understanding their roles provides insight into how the immune system functions and reacts to various stressors.
Diagnosing Low Neutrophils and High Lymphocytes
Diagnosing low neutrophil and high lymphocyte counts typically starts with a complete blood count (CBC) test. This test measures the absolute counts of different white blood cell types, offering more diagnostic value than merely looking at the total white blood cell count.
Interpreting blood test results and blood tests relies on clinical history and physical examination. A thorough assessment can reveal signs pointing to the underlying cause of abnormal counts. For instance, persistent neutropenia lasting more than six weeks usually necessitates further investigation to rule out serious conditions.
Unexplained lymphocytosis may require ongoing monitoring and possibly a referral to a hematologist. This ensures that any serious underlying conditions, such as bone marrow disorders and abnormal cells, are promptly identified and managed.
Interpreting Blood Test Results
The neutrophil-to-lymphocyte ratio (NLR) serves as a valuable marker for inflammation and immune response. A normal NLR ranges from 1 to 2, but values exceeding 3 can indicate significant health concerns, and values above 6 suggest severe inflammation.
Various factors can influence NLR readings, including chemotherapy and bone marrow disorders, which can distort these values and affect the perceived health status. Elevated NLR has been linked with increased morbidity and poor survival rates in conditions like cancer and severe infections.
Assessing the NLR aids in gauging disease severity and guiding treatment decisions in inflammatory bowel disease. It’s a crucial component in evaluating overall health and identifying potential risks.
Health Risks Associated with Abnormal Cell Counts
Low neutrophil counts signal an impaired innate immune response, increasing susceptibility to infections. Individuals with low neutrophil counts face a heightened risk of serious infections and may experience delayed wound healing.
On the other hand, high lymphocyte counts can indicate chronic inflammation, which can lead to various health issues. Chronic inflammation is linked to the development of conditions such as heart disease and cancer.
- Increased Infection Risk: Low neutrophil levels make it easier for infections to take hold.
- Chronic Inflammation: Elevated lymphocyte levels can contribute to chronic diseases.
- Serious Conditions: High lymphocyte counts can signal severe conditions like blood cancer or chronic infections.
Monitoring the neutrophil-to-lymphocyte ratio provides valuable insights into the body’s inflammatory status and overall immune function, helping in the management of chronic health conditions.
Treatment Options for Low Neutrophils
Treating low neutrophil counts involves multiple approaches. Antibiotics are crucial when neutropenia is accompanied by fever, often requiring hospital admission for intravenous administration. In cases where an autoimmune issue is causing neutrophil destruction, corticosteroids may be prescribed.
Granulocyte colony-stimulating factor (G-CSF) is used to stimulate white blood cell production in patients undergoing chemotherapy. If medications are responsible for the low neutrophil levels, doctors might adjust the dosage or recommend discontinuing the medication.
Regular monitoring of neutrophil levels is essential for individuals undergoing chemotherapy to prevent infections. Adjusting treatment doses based on neutrophil levels can minimize the risk of complications and improve patient outcomes.
Treatment Options for High Lymphocytes
Managing high lymphocyte counts often involves addressing the underlying cause. Early high-dose immunosuppressive therapy has been shown to reduce inflammation and potentially extend survival in patients with high lymphocyte counts. Clinical improvement has been seen in patients receiving high-dose steroids, highlighting a critical therapeutic window.
Antiviral medications, such as acyclovir, may be used when a viral cause is suspected. However, the effectiveness of these medications can vary based on the specific virus involved, including certain viral infections and viral infection. Combination treatments involving immunosuppressants and antiviral agents may be beneficial, although the prognosis remains poor without effective antiviral options.
In severe cases, treatment strategies might include chemotherapy or radiation therapy, especially for hematologic disorders like leukemia or lymphoma that contribute to high lymphocyte counts.
Monitoring and Follow-Up Care
Regular monitoring and follow-up care are vital for patients with low neutrophil or high lymphocyte counts. Patients should maintain open communication with their healthcare providers about any new symptoms or concerns. Doctors monitor trends in blood test results over time to guide treatment decisions.
For moderate or severe neutropenia, a referral to a hematologist might be necessary. High neutrophils and low lymphocytes on a lab report should prompt a discussion with a healthcare professional to understand the implications and necessary steps.
The neutrophil-to-lymphocyte ratio has been particularly useful during the COVID-19 pandemic, aiding in decisions about patient admission and recovery.